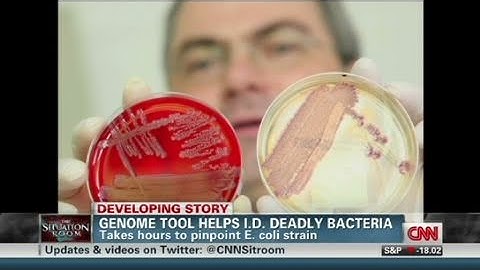
CNN: Genome tool pinpoints new E. Coli strain

⬇ DOWNLOAD NOW
Kalau muncul iklan pop-up, tutup lalu klik tombol kembali
Download lagu searching for E.coli IAI39 genome sequence secara gratis hanya untuk keperluan promosi. Dukung artis favorit kamu dengan membeli musik original di iTunes atau platform resmi lainnya.
 A genome wide analysis of heat survival mechanisms of Escherichia coli
A genome wide analysis of heat survival mechanisms of Escherichia coli
 How to Sequence a Genome: 4. E. Coli Storage
How to Sequence a Genome: 4. E. Coli Storage
 Investigating e-coli's genome to make predictions about disease
Investigating e-coli's genome to make predictions about disease
 Session 2 : Genomics for Foodborne pathogens characterization and outbreak investigation
Session 2 : Genomics for Foodborne pathogens characterization and outbreak investigation
CNN: Genome tool pinpoints new E. Coli strain
CNN: Genome tool pinpoints new E. Coli strain
 Decoding E. coli Genomics: A Detailed Look at Its Genetic Structure and Organization
Decoding E. coli Genomics: A Detailed Look at Its Genetic Structure and Organization
 Mutational waves in the E. coli genome
Mutational waves in the E. coli genome
 Comparative Genome Analysis of E. coli Strain Sanji
Comparative Genome Analysis of E. coli Strain Sanji